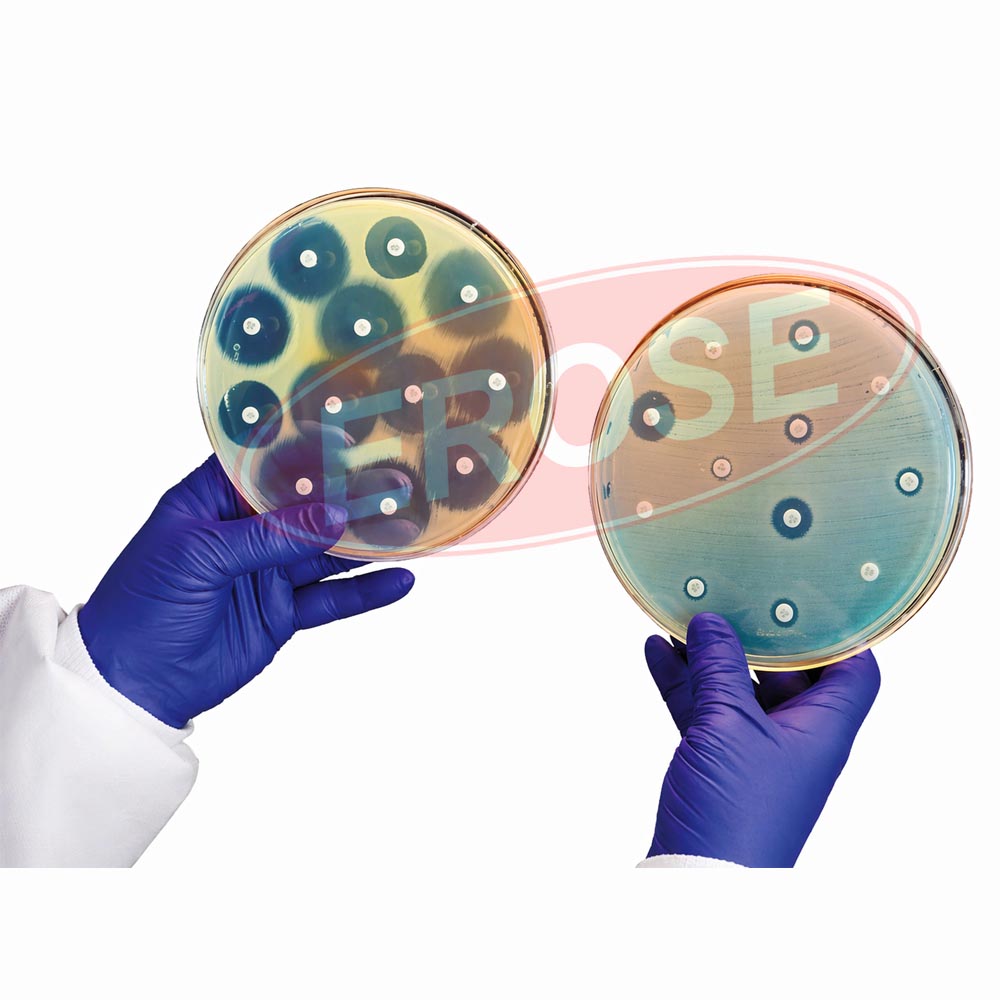
Antimicrobial Susceptibility Discs

Welcome to
Glass Agencies





Popular Categories
We are the leading Manufacturer, Supplier and Exporter of all kinds of Laboratory Glassware & Scientific equipments.
Top Selling Laboratory Glassware
We are the leading Manufacturer, Supplier and Exporter of all kinds of Laboratory Glassware, Scientific equipments.
Test Tubes
Laboratory GlasswareDesiccators Plain, Borosilicate Glass
Laboratory GlasswareJoint and Connectors
Laboratory GlasswareLaboratory Funnel
Laboratory GlasswareSquib Seperatory Funnel
Laboratory GlasswareCylinders
Laboratory GlasswareBottles
Laboratory Glassware
Top Selling Surgical Instruments
We are the leading Manufacturer, Supplier and Exporter of all kinds of Surgical Instruments
Alice Tissue Forceps
Surgical EquipmentCatspaw Retractors
Surgical EquipmentMayo Instrument Hanger
Surgical EquipmentMosquito Forceps Straight
Surgical EquipmentMosquito Forceps Curved
Surgical EquipmentUterine Manipulator
GynecologyMetal Urethral Catheter
GynecologyMICRO LARYNGEAL SET SET OF 15 INSTRUMENTS
Surgical Instruments
Top Selling Medical Instruments
We are the leading Manufacturer, Supplier and Exporter of all kinds of Medical, Hospital Instruments & Equipments.
Antimicrobial Susceptibility Discs
Medical InstrumentsDental Surgical Loupe
ENT InstrumentsAuto CPAP
Medical InstrumentsSurgical Suture Needle
Medical Disposable ProductsBattery for Surgical Headlight
Medical Instruments
Top Selling Hospital & Medical Lab Equipments
We are the leading Manufacturer, Supplier and Exporter of all kinds of Hospital & Medical Laboratory equipments.
Isoflurane, Halothane, Sevoflurane Anesthesia Vaporizer
Anaesthesia EquipmentsSyringe Infusion Pump
Hospital InstrumentsDefibrillator Machine
Hospital InstrumentsTransport Ventilator
Hospital InstrumentsICU Ventilator
Hospital Instruments
We are India’s Leading Manufacturer, Supplier and Exporter of all kinds of Scientific Products & Laboratory Glassware

Glass Agencies is a leading laboratory glassware manufacturer in India, known for its commitment to quality and innovation since 1956. As an ISO certified lab equipment exporter, we specialize in producing calibrated laboratory glassware and scientific glass apparatus that meet global standards. Our extensive range of lab solutions serves educational institutions, research centers, and pharmaceutical industries worldwide. The EROSE brand, trusted by professionals for decades, reflects our dedication to precision and performance. With a growing global presence, Glass Agencies continues to be the preferred scientific glass apparatus supplier for clients seeking accuracy, reliability, and excellence in laboratory equipment.
Why Glass Agencies
- One Source for All Equipment
- Leading Service Response Teams
- Hassle free Buying process




India's Leading Microscope Manufacturer
EROSE MICROSCOPES
As a leading manufacturer of microscopes, EROSE delivers innovative solutions and services that empower life sciences, materials research, teaching, and clinical applications. Trusted worldwide, EROSE systems are relied upon for manufacturing, high-tech assembly, as well as exploration and processing of raw materials. Discover the perfect solution for your needs from a comprehensive range of light, confocal, electron, and X-ray microscopes.

Worldwide Shipping
Shipping is based on your consignment size & other factors, contact for further details.

Dealership
Be a part of our success story and contact to become one of our authorized dealers. 24x7 Support Team just a call away.

Bulk Orders
Special Discounts on bulk orders. Regular Bulk Orders to over 56 countries worldwide. Reasonably priced, good quality products, impressive packaging and prompt delivery of Consignments.

Secure Payments
We accept Wire or Telegraphic Transfer/ Letter of Credit/ Paypal etc. ontact us for further details.
Dubai has become one of the leading business and industrial
Introduction The demand for a professional laboratory equipments supplier Nigeria
Ethiopia is rapidly emerging as a developing hub for education,